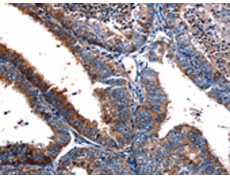
一抗

|
Background: |
Low affinity receptor for N-formyl-methionyl peptides, which are powerful neutrophils chemotactic factors. Binding of FMLP to the receptor causes activation of neutrophils. This response is mediated via a G-protein that activates a phosphatidylinositol-calcium second messenger system. The activation of LXA4R could result in an anti-inflammatory outcome counteracting the actions of proinflammatory signals such as LTB4 |
|
Applications: |
ELISA, IHC |
|
Name of antibody: |
FPR2 |
|
Immunogen: |
Synthetic peptide of human FPR2 |
|
Full name: |
formyl peptide receptor 2 |
|
Synonyms: |
ALXR, HM63, FMLPX, FPR2A, FPRH1, FPRH2, FPRL1, LXA4R, FMLP-R-II |
|
SwissProt: |
P25090 |
|
ELISA Recommended dilution: |
1000-10000 |
|
IHC positive control: |
Human cervical cancer |
|
IHC Recommend dilution: |
20-100 |

 購物車
購物車 幫助
幫助
 021-54845833/15800441009
021-54845833/15800441009